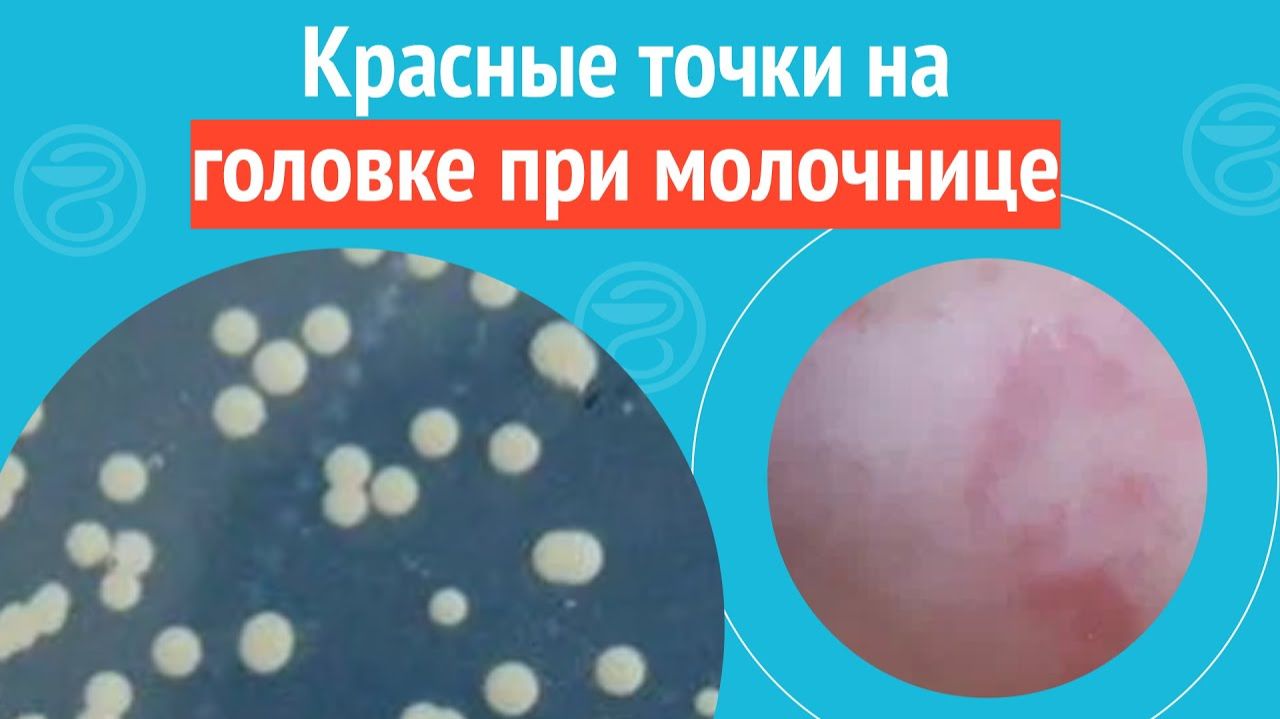
▶️ Красные точки на головке при молочнице. Клинический случай №1265

Новое видео
МИФЫ О СЕКСЕ, В КОТОРЫЕ ВЫ ВЕРИТЕ Разоблачение про секс, отношения, оргазм и либидо | Сексология

Видео: МИФЫ О СЕКСЕ, В КОТОРЫЕ ВЫ ВЕРИТЕ Разоблачение про секс, отношения, оргазм и либидо | Сексология
Мифы о сексе, в которые мы верим. Разоблачение заблуждений про секс, сексуальные отношения, оргазм, либидо и сексуальное возбуждение у девушек, женщин и мужчин. Сексология, сексолог про секс, видео. Запись на консультацию, книга и все курсы - на сайте ➡ Разоблачение мифов о сексе... Кто бы мог подумать, что такое может понадобиться в 21 веке во время развития всемирной паутины. Конечно, отчасти, она же и путает людей всё больше распространяя недоразумение в виде ложной информации, подкрепляющейся коллективной иллюзией. Благо, всё благодаря той же всемирной паутине, вы можете найти, в том числе и этот ролик, где мы подробно обсудим интересные ошибочные суждения, и кратко совсем очевидный вздор про секс и отношения между мужчиной и женщиной в этом важном для общества вопросе. ⏭ Бесплатный вебинар “Что блокирует женскую сексуальность? 10 ошибок женщин в отношении к себе и мужчинам” ▶ 00:00 - Вступление 01:23 - Миф 1: Влагалище может неизбежно увеличится от обычных вещей 04:23 - Миф 2: Член может сломаться, а грудь износиться 07:14 - Миф 3: Секс не может быть таким хорошим, как в начале 08:47 - Миф 4: Женщина всегда ищет лучшего, а мужчина новую 11:43 - Миф 5: Мужчины животные, а женщинам нужно чего-то большего 14:12 - Миф 6: Клитор может увеличиться до неадекватных размеров 14:43 - Миф 7: Партнёрские роды могут негативно сказаться на возбуждении мужчины 16:26 - Миф 8: Если женщина не испытывает оргазм, то, от этого начнутся болезни 18:25 - Миф 9: Никогда не рожавшие женщины с возрастом могут столкнуться с гинекологическими проблемами 19:11 - Миф 10: Если у женщины отсутствует естественная смазка, значит она не хочет своего мужчину 20:41 - Миф 11: Телегония 21:16 - Миф 12: Секс при месячных опасен? ⏭ Рекомендую посмотреть МИФЫ О СЕКСЕ: Часть 1 ▶ Часть 2 ▶ Вот о каких вопросах пойдет речь в видео: Влагалище изнашивается от большого количества секса? Таким хорошим, как в начале отношений, секс никогда не будет? Возможно ли сохранить секса таким же хорошим, как в начале отношений? Женщина ищет лучшего, а мужчина новую. Так заложено природой. Правда ли это? Мужчины готовы к сексу сразу, а женщинам нужно привыкнуть к человеку. Правда ли, что мужской секс более животный? Мужчине кончить проще, чем женщине. Всегда ли это так? Трудности с оргазмом традиционно считались женской проблемой, а сталкиваются ли мужчины с невозможностью кончить? От мастурбации увеличивается клитор и сильнее накрывается капюшоном, так ли это? Партнёрские роды пагубны для либидо мужчины? Если не испытывать оргазм, будет застой крови, а от этого болезни? Старые девы болеют от отсутствия секса и бездетности? Если женщина сухая, значит она не возбуждена и ничего не хочет? Телегония существует? Секс при месячных опасен? Как правильно заниматься сексом при месячных? #секс #сексолог #отношения #сексология #мифыосексе #мифы #психология Если вы нашли это видео, то скорей всего искали: мифы о сексе, мифы в которые мы верим, мифы про секс, разоблачение мифов о сексе, мифы про секс разоблачение, мифы о сексе разоблачение, про мифы о сексе, секс мифы, про сексуальные отношения, сексология, сексолог, секс отношения, сексуальное возбуждение, либидо, женский оргазм, про оргазм, факты о сексе, психология секса,
Присоединяйтесь к обсуждению